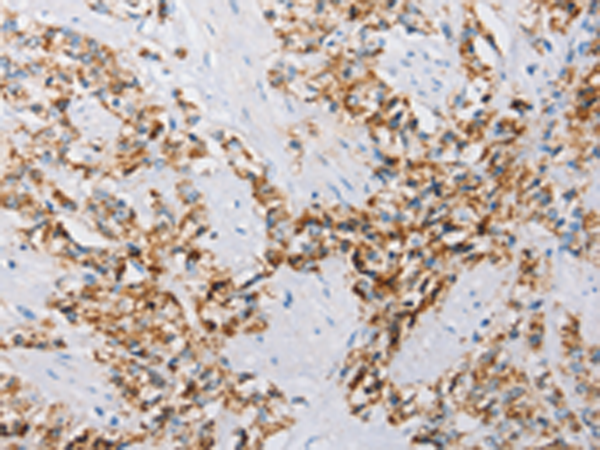

ATG4C Rabbit Polyclonal Antibody
Other products for "ATG4C"
Specifications
| Product Data | |
| Applications | IHC, WB |
| Recommended Dilution | WB: 200-1000 WB positive control: Mouse brain tissue IHC: 25-100 Positive control: Human prostate cancer Predicted cell location: Cytoplasm |
| Reactivities | Human, Mouse |
| Host | Rabbit |
| Isotype | IgG |
| Clonality | Polyclonal |
| Immunogen | Fusion protein of human ATG4C |
| Formulation | pH7.4 PBS, 0.05% NaN3, 40% Glyceroln |
| Concentration | lot specific |
| Purification | Antigen affinity purification |
| Conjugation | Unconjugated |
| Storage | Store at -20°C as received. |
| Stability | Stable for 12 months from date of receipt. |
| Predicted Protein Size | 52 kDa |
| Gene Name | autophagy related 4C cysteine peptidase |
| Database Link | |
| Background | Autophagy is the process by which endogenous proteins and damaged organelles are destroyed intracellularly. Autophagy is postulated to be essential for cell homeostasis and cell remodeling during differentiation, metamorphosis, non-apoptotic cell death, and aging. Reduced levels of autophagy have been described in some malignant tumors, and a role for autophagy in controlling the unregulated cell growth linked to cancer has been proposed. This gene encodes a member of the autophagin protein family. The encoded protein is also designated as a member of the C-54 family of cysteine proteases. Alternate transcriptional splice variants, encoding the same protein, have been characterized. |
| Synonyms | APG4-C; APG4C; AUTL1; AUTL3 |
| Reference Data | |
| Protein Families | Protease |
| Protein Pathways | Regulation of autophagy |
Documents
| Product Manuals |
| FAQs |
{0} Product Review(s)
0 Product Review(s)
Submit review
Be the first one to submit a review
Product Citations
*Delivery time may vary from web posted schedule. Occasional delays may occur due to unforeseen
complexities in the preparation of your product. International customers may expect an additional 1-2 weeks
in shipping.






























































































































































































































































 Germany
Germany
 Japan
Japan
 United Kingdom
United Kingdom
 China
China